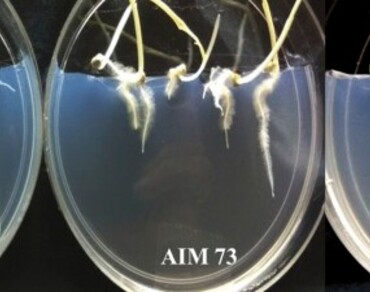
Prevalance of multifunctional Azospirillum formosense strains in the rhizosphere of pearl millet across diverse edaphoclimatic regions of India

Vol 36 Issue 3, September 2023
Total Articles: 42

Pathogenic potential of seed mycobiota of Helianthus annuus L.
Research Articles
Views: 3775
Pages: 1101-1104
Published: 30 November, 2022
Doi: 10.1007/s42535-022-00498-w

Soil quality, carbon stock and climate change mitigation potential of Dipterocarp natural and planted forests of Tripura, Northeast India
Research Articles
Views: 3697
Pages: 1105-1118
Published: 07 December, 2022
Doi: 10.1007/s42535-022-00515-y
Prevalance of multifunctional Azospirillum formosense strains in the rhizosphere of pearl millet across diverse edaphoclimatic regions of India
Research Articles
Views: 4124
Pages: 1119-1129
Published: 24 December, 2022
Doi: 10.1007/s42535-022-00537-6

Transcriptome analysis reveals upregulated secondary metabolite pathways in micropropagated Lawsonia inermis L.
Research Articles
Views: 3300
Pages: 1130-1138
Published: 19 April, 2023
Doi: 10.1007/s42535-023-00613-5

Correction: Eco friendly synthesis of TiO2 nanoparticles using aqueous Ocimum americanum L. leaf extracts and their antimicrobial, anti-proliferative and photocatalytic activities
Correction
Views: 3162
Pages: 1139-1139
Published: 20 April, 2023
Doi: 10.1007/s42535-023-00596-3

Author Correction: Biogenic synthesis of selenium nanomaterial and its application as anti-nematode booster in Solanum lycopersicum (Tomato)
Author Correction
Views: 3133
Pages: 1140-1140
Published: 28 April, 2023
Doi: 10.1007/s42535-023-00637-x